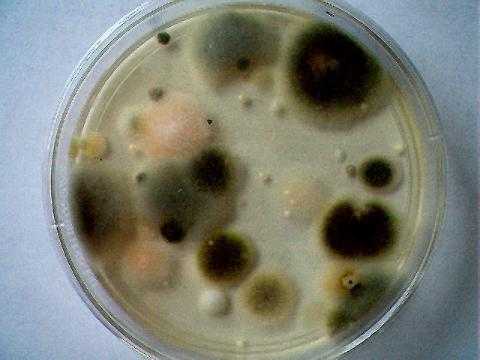
виды плесневых грибов
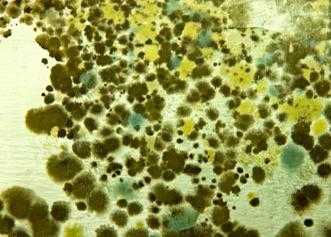
строение плесневых грибов
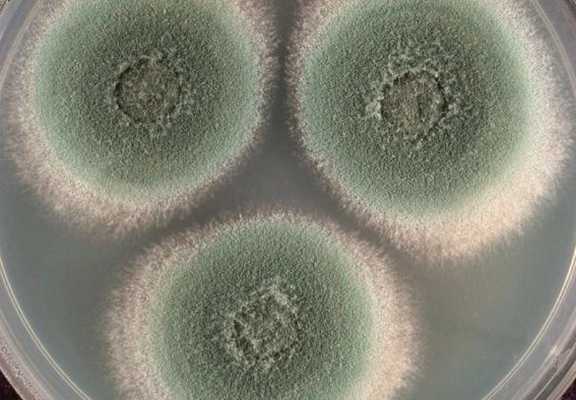
клетка плесневого гриба
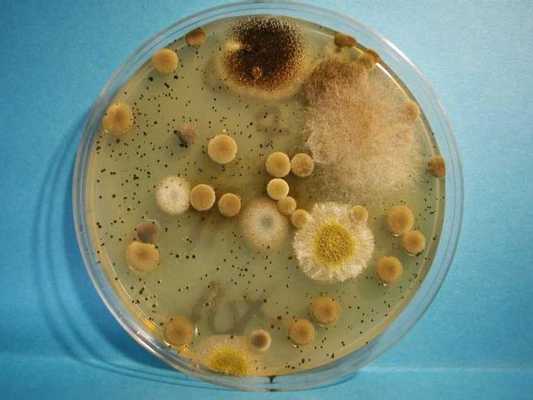
плесневые грибы и бактерии

Дрожжи. Дрожжеподобные грибы. Бластоконидии. Плесневые грибы. Рост плесневых грибов. Диморфизм грибов.
Добавил пользователь Валентин П. Обновлено: 01.02.2026
Гифальные(плесневые) грибы образуют ветвящиеся тонкие нити (гифы), сплетающиеся в грибницу, или мицелий (плесень). Гифы, врастающие в питательный субстрат, называются вегетативными гифами (отвечают за питание гриба), а растущие над поверхностью субстрата — воздушными или репродуктивными гифами (отвечают за бесполое размножение).
Гифы низших грибов не имеют перегородок. Они представлены многоядерными клетками и называются ценоцитными.
Гифы высших грибов разделены перегородками, или септами с отверстиями.
Дрожжевыегрибы (дрожжи), в основном, имеют вид отдельных овальных клеток (одноклеточные грибы). По типу полового размножения они распределены среди высших грибов — аскомицет и базидиомицет. При бесполом размножении дрожжи образуют почки или делятся, что приводит к одноклеточному росту. Могут образовывать псевдогифы и ложный мицелий (псевдомицелий) в виде цепочек удлиненных клеток — «сарделек». Грибы, аналогичные дрожжам, но не имеющие полового способа размножения, называют дрожжеподобными. Они размножаются только бесполым способом — почкованием или делением.
Грибы размножаются спорами половым и бесполым способами, а также вегетативным путем (почкование или фрагментация гиф). Грибы, размножающиеся половым и бесполым путем, относятся к совершенным. Несовершенными называют грибы, у которых отсутствует или еще не описан половой путь размножения. Бесполое размножение осуществляется у грибов с помощью эндогенных спор, созревающих внутри круглой структуры — спорангия, и экзогенных спор — конидий, формирующихся на кончиках плодоносящих гиф.
МОРФОЛОГИЯ АКТИНОМИЦЕТ. Актиномицеты - это ветвящиеся грам+ бактерии. Клетки актиномицет имеют те же структурные элементы, что и бактерии: клеточную стенку, ЦПМ, нуклеоид, рибосомы, мезосомы, внутриклеточные включения. Некоторые актиномицеты образуют микрокапсулу; жгутиков не имеют, истинных спор не образуют. На концах некоторых актиномицетов образуются одна или несколько экзоспор, которые являются органами плодоношения. Спороносцы актиномицетов прямые, волнистые и спиральные; споры крупные овальные и цилиндрические с гладкой волосистой, бородавчатой или шиловидной поверхностью. Актиномицеты, как и грибы, образуют мицелий —нитевидные переплетающиеся клетки (гифы). Они формируют субстратный лицелий, образующийся в результате врастания мицелия в питательную среду, и воздушный, растущий на поверхности среды. Спороносцы располагаются на концах гифов. Гифы актиномицет могут распадаться на палочки и кокки. Размеры актиномицет колеблются от 5,0- 7,0 до 100 мкм и более в длину и 0,5-2 мкм в ширину. Легко окрашиваются многими анилиновыми красителями грам+. Размножаются простым поперечным делением, путём прорастания гиф и спор, почкованием. Роль актиномицет. В почве они участвуют в разложении сложных веществ (клетчатки, неорганических полимеров). Стрептомицеты продуцируют антибиотики. Ряд видов обитает в ротовой полости, дыхательных путях, кишечнике и на коже человека. Они вызывают образование зубного налёта, зубного камня, но и играют роль фактора антиинфекционной защиты, так как являются антагонистами бактерий, микоплазм и грибов. Патогенные актиномицеты вызывают у человека актиномикоз и нокардиоз. МОРФОЛОГИЯ ГРИБОВ. Морфология. Форма клеток у молодых культур может быть круглая, яйцевидная или удлинённая; у зрелых клеток - грушевидная, булавовидная, веретенообразная, амёбовидная. По строению грибы сходны с водорослями: они обладают дифференцированным ядром (одним или несколькими), клеточной стенкой, ЦПМ. Цитоплазма у молодых культур гомогенная, у зрелых - зернистая; в ней находятся митохондрии, аппарат Гольджи, вакуоли, различные включения (гликоген, волютин, липиды, пигменты, кристаллы органических солей). Основным структурным компонентом клеток грибов является мицелий, состоящий из разветвлённых бесцветных нитей (гиф) 1-10 мкм в диаметре и 4 - 70 мкм длиной. У одних видов он состоит из нерасчленённой клетки (Мисочголовчатая плесень), у других (высших грибов) он многоклеточный; у дрожжеподобных грибов (Candida) имеется псевдомицелий. У низших грибов от мицелия отходит спорангиеносец, на конце которого находится спорангий, в котором внутри созревают эндогенные споры. У высших грибов от мицелия отходит конидиеносец, на конце которого расположены конидии - экзогенные споры.
Архимицеты (простейшие грибы) - вегетативное тело представлено протоплазмой, ограниченной цитоплазматической мембраной, реже - зачаточным мицелием. Они являются паразитами водорослей. Фикомицеты - мицелий этих грибов без перегородок, одноклеточный. Среди этих грибов встречаются сапрофиты и паразиты. К этому классу относятся мукоровые грибы. Тело мукоровых грибов состоит из мицелия в виде сильно разветвленной клетки, от которой ответвляются плодоносящие гифы - спорангионосцы с шарообразным расширением наверху - спорангиями, наполненными эндоспорами, выполняющими функцию размножения. Аскомицеты имеют хорошо развитый, многоклеточный мицелий. Среди аскомицетов имеются паразиты и сапрофиты. Например, род Aspergillus. У человека грибы этого рода вызывают поражение кожи, придаточных полостей носа, легких, бронхов, роговицы глаза, наружного слухового прохода, иногда костей и других органов и тканей. К классу аскомицетов также относится род Penicillium. В класс Ascomycetes, порядок Saccharomycetales (первично сумчатые грибы) включены дрожжи, которые представляют собой крупные клетки овальной, шаровидной и палочковидной формы. Базидиомицеты объединяют большое количество шляпочных грибов. Дейтеромицеты - несовершенные грибы (Fungi imperfecti). Очень большая группа грибов. Они обладают многоклеточным мицелием, имеют конидии. Размножение бесполое. Эта группа включает патогенные для человека грибы: триходерму, альтернарию, кандиду, микроспориум, фузарии и другие.
1. У высших грибов (эумицетов) гифы разделяются на отдельные клетки перегородками (септами) и их мицелий характеризуется как септированный. Септы могут иметь отверстия, позволяющие цито-плазме и даже некоторым органоидам перетекать из одной клетки в другую.
2. Гифы низших грибов (фикомицетов) лишены перегородок, их мицелий называется несептированным, а сами гифы - ценоцитными.
б. Ту часть таллома, которая врастает в питательный субстрат, называют субстратным (вегетативным) мицелием, а ту, которая формирует споры - воздушным (репродуктивным) мицелием. Воз-душный мицелий образуют специализированные гифы, несущие репродуктивные структуры - споро-форы, в которых и развиваются споры гриба.
1. Споры, развивающиеся внутри терминально увеличенного конца гифы, называются эндоспоры, они заключены в специальные мешкообразные структуры - спорангии. Гифа, в которой формируются спорангии называется спорангиофорой. Такой тип спорообразования присущ, например, грибам рода Mucor.
2. При другом типе спорообразования споры располагаются на поверхности спорофоры и называются экзоспорами или конидиями, а соответствующая гифа - конидиофорой. Строение конидий и их количество у грибов разных видов широко варьируют; кроме того, конидии могут быть как одноклеточ-ными (микроконидии), так и многоклеточными (макроконидии).
а. Конидиефоры грибов рода Aspergillus заканчиваются терминальными пузырьками или головками, в которые врастают бутылкообразные конидии - стеригмы.
б. У конидиефоров грибов рода Penicillium на терминальном конце вместо головки разви-вается путём деления специализированная кисточка (поэтому эти грибы называются леечной плесе-нью).
в. Иногда конидии могут формироваться при фрагментации конидиофора, в этом случае для их обо-значения используется термин артроконидии.
в. Плесневые грибы идентифицируются по характеру колоний, но главную роль в их дифференциации играют описанные выше морфологические особенности репродуктивных структур, выявляемые при микроскопии.
г. У плесневых грибов существует половой и вегетативный типы размножения. Структуры, развивающиеся после оплодотворения, в клиническом материале, как правило, не выявляют. Инфекционными агентами плесеней являются споры. Плесневые грибы классифицируются поэтому и по способу образования и прорастания спор.
1. У низших грибов споры образуются половым путём с кариогамией и последующим мейозом.
а. С изогамией после слияния гамет образуются зигоспоры.
б. С гетерогамией после слияния сперматозоидов и оосфер образуются ооспоры.
2. У высших грибов споры классифицируются по прорастания.
а. Базидиоспоры отшнуровываются от базидия - концевой клетки мицелия. Количество базидиоспор обычно равно 4, реже - 2 или 1.
б. Аскоспоры образуются в специализированных булавовидных (реже - шаровидных) структурах, называемых асками. Число аскоспор всегда чётное. Аски могут заключаться в перитеций. Это особый орган, который представляет собой коробочку, сплетённую из мицелиальных клеток.
2. Дрожжи и дрожжеподобные грибы - одноклеточные организмы.
а. Морфология дрожжей различных видов схожа - это сферические или овоидные клетки от 3 до 15 мкм в диаметре.
б. Большинство видов дрожжей размножаются почкованием и лишь немногие виды - бинарным делением. Конидии дрожжей, отпочковывающиеся от материнской клетки, называются бластоконидия-ми. У некоторых видов бластоконидии могут удлиняться с образованием псевдогиф. Такое явление наблюдается, например, у Candida albicans.
в. Дрожжи идентифицируются по биохимическим признакам (прежде всего - по утилизации углеводов) и другим метаболическим признакам, а также по данным микроскопии.
3. И у плесеней и у дрожжей может наблюдаться диморфизм. Это феномен морфологического полиморфизма, когда один и тот же вид может быть как мицелиальным (гифальным), так и дрожжеподобным; может быть проявлением, например, адаптации гриба к изменившимся условиям окружающей среды.
Поверхн. Микоз
Malassezia furfur (ранее Pityrosporum orbicularae) и M. globosa - широко распространенные дрожжеподобные липофильные грибы, обитающие в норме на коже человека. Вызывают отрубевидный (пестрый, разноцветньгй) лишай, характеризующийся появлением на коже туловища, шее, руках розовато-желтых невоспалительных и гипопигментированных пятен. При соскабливании на пятнах появляются чешуйки, похожие на отруби. В чешуйках, обработанных 20% щелочью, выявляются короткие изогнутые гифы и дрожжеподобные почкующиеся клетки грибов. Их выращивают на средах, содержащих липидные компоненты и твин-80. Колонии лучше растут под слоем стерильного оливкового масла. Рост отмечается через неделю в виде сливкообразных беловато-кремовых колоний, состоящих из овальных, бутылкообразных почкующихся клеток размером 2x6 мкм. Лечение амфотерицином B, итраконазолом, кетоконазолом, флуконазолом.
Дерматофиты имеют септированный мицелий с артроконидиями, хламидоспорами, макро- и микроконидиями (см. рис.18.1). У грибов рода Epidermophyton имеется множество гладких дубинкообразных макроконидий, а у представителей рода Microsporum - толстостенные, многоклеточные, веретенообразные с шипами микроконидии. Для грибов рода Trichophyton характерны крупные гладкие септированные макроконидии.
Грибы размножаются бесполым (анаморфы) или половым (телеоморфы) путем. Растут на среде Сабуро и др. Колонии (в зависи- мости от вида) разноцветные, мучнистые, зернистые, пушистые.
Гифа (от др.-греч. ὑφή — паутина) — нитевидное образование у грибов, состоящее из многих клеток или содержащее множество ядер.
Различают септированные гифы (многоклеточные) и несептированные гифы (представленные одной гигантской многоядерной клеткой). В случае септированных гиф в клеточных перегородках могут оставаться отверстия, через которые цитоплазма и органоиды (включая ядра) свободно перетекают из клетки в клетку.
Отдельные гифы нарастают путём верхушечного роста, по своему ходу они могут сильно ветвиться. Гифы способны объединяться в продольные группы, образуя более крупные (в несколько метров длиной и несколько миллиметров шириной) тяжи — Более плотные сплетения гиф формируютсклероции из которых могут образовываться органы плодоношения. Совокупность гиф гриба составляет мицелий (грибницу).
Плотно переплетённые группы гиф в плодовых телах грибов образуют ложную ткань, или плектенхиму (псевдопаренхиму). Плектенхима напоминает обыкновенную паренхиму, но она образована не трёхмерно делящимися клетками, а плотно сближёнными тяжами гиф.
Основная функция гиф — поглощение воды и питательных веществ. Некоторые гифы специализируются и преобразуются в гаустории (органы «перекачивания» воды и питательных веществ), ловчие петли (у хищных грибов) и др. Совокупность гиф образует плектенхиму или мицелий.
Аскоспора — спора, содержащаяся или образующаяся в аске (сумке). Этот тип спор характерен для грибов отдела аскомицетовОдна аска содержит чаще всего восемь аскоспор, но у некоторых видов их может быть больше или меньше (от 4 до 128) [1] . Эти восемь спор образуются в результате комбинации мейоза и последующего митотического деления клетки. Мейоз превращаетядро исходной диплоидной клетки (зиготы) в четыре гаплоидные. Перед мейозом ДНК обоих наборов хромосом зиготыреплицируется (удваивается), так что хромосомы двойного набора становятся двуххроматидными. Ядро, которое содержит два набора двуххроматидных хромосом, делится в две стадии, разделяясь на четыре новых ядра. Каждое из них имеет одинарный (гаплоидный) набор однохроматидных хромосом. После этого процесса каждое из четырёх новых ядер снова удваивает ДНК и делится митозом. В результате образуется аска с четырьмя парами спор.
Базидиоспоры (лат. basidiosporae) — репродуктивные споры базидиальных грибов (Basidiomycota), образующиеся на специализированных клетка — базидиях. Как правило, на каждой базидии образуются четыре одноядерных базидиоспоры, хотя существуют и исключения, в частности шампиньон двуспоровый. Ядра базидиоспор образуются в результате мейотического деления, происходящего в базидии, и обладают гаплоидным набором хромосом. При попадании в благоприятные условия базидиоспоры прорастают, обычно формируя гифы, в неблагоприятных условиях базидиоспоры могут при прорастании образовывать вторичные балистоспоры.
Кони́дии (от др.-греч. κονία — пыль и εἶδος — вид, образ), или конидиоспо́ры, — неподвижные споры бесполого размножения у грибов. Также известны как митоспоры, поскольку образуются в результате митоза. Они являютсягаплоидными клетками, генетически идентичными гаплоидным родительским. При благоприятных условиях развиваются в новый организм и способствуют распространению, то есть служат как для размножения, так и для расселения.
Конидии постоянно присутствуют в воздухе, но их содержание ежедневно варьирует, в том числе в зависимости от времени года. В среднем человек вдыхает 40 конидий в час [
Морфология микроорганизмов. Лекция 1. Морфология грибов
Грибы особая группа микроорганизмов,
составляющие царство Mycota;
Включают более 100 000 видов, из
которых 150 патогенные, 350 вызывают
порчу пищевых продуктов.
Грибы сочетают в себе признаки растений
и животных.
3. С растениями их сближает:
Поглощение
пищи осмотрофно.
Неограниченный
Необходимость
апикальный рост.
прикрепления к
субстрату.
Размножение
Способность
спорами.
к синтезу витаминов.
4. Черты сходства с животными:
Гетеротрофность.
Наличие в составе клеточной стенки
хитина, характерного для наружного
скелета членистоногих.
Накопление гликогена как запасного
вещества.
Образование и выделение продукта
метаболизма — мочевины.
5. Классификация
Царство: грибы
Классификация
Отряд: слизевики;
истинные грибы.
Класс:
Zygomycetes
Ascomycetes
Deuteromycetes
Oomycetes
Basidiomycetes
Несовершенные
Chitridiomycetes
Высшие
Низшие
6. Особенности биологии грибов
Грибы - эукариоты
Клеточная стенка состоит из
полисахаридов (маннанов, глюканов,
целлюлозы, хитина), белков, липидов.
Функции клеточной стенки:
Скелетная
Защитная
Рецепторная
Транспортная
ЦПМ содержит гликопротеины,
фосфолипиды и эргостеролы.
7. Морфология грибов
8. Морфология плесневых грибов
Вегетативное тело грибов — это
мицелий, состоящий из тонких
гиф.
Гифа - многоядерная нитевидная
клетка с неограниченным ростом и
боковым ветвлением.
9. Мицелий может быть:
У низших грибов
несептированный представлен
разветвлениями одной
гифы без перегородок.
У высших грибов
септированный -
гифы разделены
перегородками (септами)
и имеют общую оболочку.
10. Мицелий дифференцируется на:
Субстратный или
вегетативный,
служащий для прикрепления
к субстрату, поглощения и
транспортировки воды и
растворенных в ней веществ.
Воздушный или
репродуктивный,
поднимающийся над
субстратом и образующий
органы размножения.
11. Вегетативное размножение плесневых грибов
происходит:
частями мицелия
почкованием клеток
атроспорами - возникают
в результате распада гиф
на отдельные клетки
Вегетативное размножение:
Преимущество
Примитивность
- Обеспечивает быструю
колонизацию пораженных
тканей.
-Отсутствие специальных структур
-Образование генетически
однородных особей
12. Бесполое размножение плесневых грибов
Осуществляется
посредством спор.
Спора - зародышевая
клетка гриба, покрытая
пятислойной оболочкой.
Споры могут быть:
Низшие грибы
Высшие грибы
Эндогенные образуются
внутри спорангиев.
Экзогенные или конидии
возникают открыто на
концах конидиеносцев.
В благоприятных условиях, спора прорастает,
и из нее формируется новый мицелий
13. Половое размножение плесневых грибов
Сущность в слиянии половых
клеток - гамет, в результате
образуется зигота.
Гаметы - гаплоидный набор
хромосом.
Зигота - диплоидный набор
хромосом.
Зигоспоры
Аскоспоры
Преимущества:
Базидиоспоры
Формируются
неидентичные
особи.
Адаптаця к внешним условиям.
14. Фазы развития грибов
Трофофаза - высокая скорость
размножения и низкая продукция
метаболитов
Идиофаза - низкая скорость
размножения гриба и высокая
метаболическая активность
При воздействии химиотерапевтических
препаратов, снижение питательной
ценности субстрата грибы формируют
покоящиеся формы
Хламидоспора - гифальная клетка
увеличенных размеров, покрытая плотной
оболочкой
Склероции - скопления плотно
переплетенных гиф
17. Chitridiomycetes
Мицелия нет или он
находится в зачаточном
состоянии.
Бесполое размножение при
помощи одножгутиковых
подвижных зооспор.
Половой процесс - слияние
одинаковых или разных по
размеру гамет
(изогамия,гетерогамия).
Некоторые представители - внутриклеточные паразиты
возбудители болезней растений - поражают капустную
рассаду и картофель.
18. Oomycetes
Мицелий неклеточный.
Бесполое размножение
зооспорами с двумя
жгутиками, из которых
один перистый.
Половой процесс с
помощью ооспор.
Паразиты растений
фитофтора - клубни и ботву
картофеля
плазмопара - виноград
пероноспора - сахарную свеклу
19. Zygomycetes
Мицелий несептированнный,
многоядерный.
Половое размножение
происходит с помощью зигоспор
Бесполое размножение
осуществляется эндоспорами.
Pacпpoстранены в почве и
воздухе.
Поражают корнеплоды в
период хранения, вызывая
белую или серую гниль
Некоторые
мукоровые
продуцируют
органические
кислоты и
сбраживают
сахар и
этиловый
спирт
Мукор на хлебе
21. Ascomycetes
Мицелий септированный,
многоклеточный.
Половое размножение при
помощи аскоспор -
развиваются в особых сумках асках.
Бесполое размножение
осуществляется конидиями.
К аскомицетам относятся
Плодосумчатые (аспергилл,
пеницилл)
Голосумчатые (спорынья)
сахаромицеты
кандида
Род Aspergillus
Конидиеносцы прямостоящие,
на концах шаровидное вздутие,
несущее стеригмы,
расположенные радиально на
поверхности всего вздутия.
«Леечная» плесень
применяется для производства
лимонной кислоты, спирта и
пива
Род Penicillium
Конидиеносцы
многоклеточные, которые
разветвляются в верхней
части и заканчиваются
стеригмами, расположенными
в виде кисточек.
Пенициллы используются для
производства пенициллина и
плесневых сыров типа рокфор
24. голосумчатые
Спорынья:
-паразит злаковых растений. В колосе
образуются склероции - образования
темно-фиолетового цвета
- Возбудитель «меловой болезни хлеба» - в
мягкой части образуются белые сухие пятна
25. Basidiomycetes
Мицелий септированный,
развитый.
Половое размножение с
помощью базидиоспор,
образующиеся экзогенно
на базидиях.
Бесполое размножение
осуществляется
конидиями.
• Шляпочные грибы
• Трутовики - опасные
разрушители живой
древесины
• Домовые грибы специфические
разрушители строительной древесины
• Головнёвые -
поражают зерновые культуры
• Ржавчинные - поражают злаковые
растения и подсолнух
27. Deuteromycetes
Мицелий септированный,
многоклеточный.
Размножаются только
бесполым путем в
результате
формирования конидий.
Плесневение пищевых продуктов, ткани, шерсти,
бумаги
1. Кладоспориум - при хранении пищевых
продуктов в холодильнике. Образуется
бархатистая пленка темно-оливкового цвета
2. Ботритис -порча лука, капусты, моркови,
томатов и ягод
3. Альтенария - поражает корнеплоды при
хранении «черная гниль»
4. Оидиум - «молочная плесень на квашенной
капусте, сливочном масе и сыре»
5. Фузариум - сухая гниль картофеля
29. Дрожжи и дрожжеподобные
30. Классификация дрожжей
Дрожжи, способные к спорообразованию, называются
истинные.
• Грибы, необразующие спор, называют дрожжеподобными
(порча).
31. Морфология дрожжевых грибов
Дрожжи - неподвижные
одноклеточные эукариоты.
Клетки дрожжей имеют
овальную, яйцевидную или
эллиптическую форму.
Размножение:
Вегетативное
Бинарное
Бесполое
Половое
• Хлопьевидные - оболочка ослизняется, в
жидкой среде они склеиваются и оседают на
дно в виде хлопьев.
• Пылевидные - оболочка не склеивается,
находится во взвешенном состоянии.
33. Морфология дрожжеподобных грибов
Дрожжеподобные грибы
отличаются от истинных
дрожжей способностью
образовывать
псевдомицелий.
Структурно он отличается от
мицелия плесневых грибов
отсутствием общей
оболочки
Размножаются
почкованием.
По природе:
- культурные (делятся на рассы);
- дикие дрожжи ( в окружающей среде, вызывают
порчу продуктов).
35. Диморфизм грибов
Диморфизм - способность к гифальному
или дрожжеподобному росту, в
зависимости от условий
культивирования
В
пораженной ткани - дрожжеподобные
клетки.
На питательных средах - в форме
плесневых грибов (образуют гифы и
мицелий)
36. Физиология грибов
Питание грибов осмотическим путем.
Высокий тургор.
По типу дыхания - аэробы, нуждаются в
углекислом газе.
По типу питания - гетеротрофы
Водород и кислород получают из воды.
Азот из белков, поэтому для культивирования используют
среды содержащие сыворотку крови, экстракты тканей.
Углерод из многоатомных спиртов и сахаров, поэтому
добавляют в питательные среды глюкозу или мальтозу.
. Наиболее благоприятными средами для
культивирования грибов являются среда
Сабуро и сусло-агар.
При культивировании требовательны к
микроэлементам, температуре (37’C), pH.
Морфология микробов-эукариотов: дрожжевых и плесневых грибов
Грибы (тип Mycota, Mycetes, Fungi) представлены одноклеточными или многоклеточными эукариотами, которые по наличию хитина в оболочке, стероидов в цитоплазматической мембране и гликогена в цитоплазме напоминают клетки животного происхождения, а по наличию клеточной стенки, состоящей из полисахаридов, близких к целлюлозе; по способности к неограниченному росту, размножению спорами и неподвижностью в вегетативном состоянии - растения.
У грибов существует 2 типа роста: гифальный рост (гифомицеты) и дрожжевой рост (бластомицеты). Обычно вегетативное тело гифомицетов состоит из нитей толщиной около 5 мкм, сильно разветвленных и называемых гифами. Гифы либо не имеют поперечных перегородок (у низших грибов), либо разделены перегородками на клетки (у высших грибов). Совокупность гифов образует мицелий - грибницу (рис.1.10).

Рис. 1.10. Структура мицелия плесеней.
Мицелий может быть субстратный, образующийся в результате врастания гифов в питательную среду и воздушный, растущий на поверхности среды. Мицелий представляет ветвящиеся трубки, ветвление осуществляется боковыми выростами гиф. Переплетающиеся гифы с толстыми оболочками образуют склероции - округлые или неправильной формы образования размером от долей мм до нескольких см, предназначенные для выживания в неблагоприятных условиях (рис. 1.11).

Кроме гифальных форм грибов, существуют и бластомицеты (дрожжевые и дрожжеподобные грибы). Они представляют собой сферические или грушевидные формы размером 3-15 мкм. Эти клетки содержат включения гликогена и липиды, они способны к почкованию, делению, в результате которого клетки не распадаются, а образуют псевдомицелий.
Для многих видов грибов может быть характерен диморфизм, т. е. гифальная форма роста может переходить в дрожжеподобную.
Ни один из вышеописанных морфологических элементов не является характерным для того или иного гриба. Комплексом разнообразных клеточных элементов определяется большой полиморфизм грибов в культурах на различных питательных средах. Тканевые формы грибов обычно представлены довольно однообразными спорами или мицелием, совсем не похожими на культуральные элементы грибов.
В биотехнологии грибы используются как продуценты органических кислот (лимонной - Aspergillus niger), ферментов (амилаз -Aspergillus oryzae; пектиназ - Aspergillus awanori; каталазы - Penicillium vitale и др.), липидов, антибиотиков (пенициллина - Penicillium notatum; гризеофульвина - Penicillium griseofulvum), а также используются в пищевой промышленности (например, для созревания сыров рокфор и камамбер, получения вина, спирта, при хлебопечении и т. д.).
Классификация грибов основные классы и особенности
Основы микробиологии: классификация грибов и их строение. Классификация грибов, основные классы и особенности Грибы загадочного происхождения
Оглавление темы «Систематика живых организмов. Таксономия. Номенклатура. Классификация микроорганизмов.»:
1. Систематика живых организмов. Таксономия. Номенклатура.
2. Классификация микроорганизмов. Принципы классификации микроорганизмов. Систематика микроорганизмов. Естественная (филогенетическая) систематика микроорганизмов.
3. Искусственная (ключевая) систематика микроорганизмов. Определитель бактерий Берджи.
4. Принципы таксономии микроорганизмов. Принципы номенклатуры микроорганизмов. Категории таксономической иерархии. Названия таксонов у микроорганизмов.
5. Систематика вирусов. Особенности классификации вирусов. Основные критерии таксономической классификации вирусов.
6. Систематика бактерий. Окраска по Граму. Грамположительные бактерии. Грамотрицательные бактерии. Кислотоустойчивые бактерии.
7. Подвижность бактерий. Скользящие бактерии. Плавающие бактерии. Аэробные бактерии. Анаэробные бактерии. Факультативные бактерии.
8. Определитель Берджи. Группы бактерий определителя Берджи.
10. Систематика простейших. Принципы классификации простейших. Тип Sarcomastigophora. Тип Ciliophora. Тип Apicomplexa.
Грибы отнесены к царству Fungi (Mycota), подразделяемому на отделы Мухотусоta (грибы слизевики) и Eumycota (истинные грибы). Истинные грибы, гифы которых не имеют пepeгoродок, известны как низшие грибы. К ним относят классы Chrytidiomycetes, Hyphochrytidiomycetes, Oomycetes, Zygomycetes. Представители классов Ascomycetes, Basidiomycetes и Deuteromycetes -высшие грибы, так как их гифы имеют перегородки-септы. К ним относят подавляющее большинство видов, вызывающих заболевания у человека.
Зигомицеты [от греч. zygon, сочленение, + mykes, гриб] представлены быстрорастущим видами, обычно обитающими в почве. При культивировании in vitro образуют обильный сероватый или белый воздушный мицелий. Их гифы не имеют перегородок либо септированы части1 но. Размножаются половым и бесполым путём (см. рис. 2-10, 2-11). Бесполое размножение реализуется через образование спорангиофоров со спорангиями. Половое размножение приводит к образованию зигот — зигоспор. Поражения человека носят выраженный оппортунистический характер. Их возбудителями могут быть представители родов Absidia, Mortierella, Mucor, Rhizopus, Entomophthora, Conidiobolus и Basidiobolus.
Аскомицеты [от греч. askos, сумка, + mykes, гриб] получили своё название из-за наличия основного органа плодоношения — сумки, содержащей 4 или 8 гаплоидных половых аскоспор. Гифы имеют выраженные перегородки. Размножаются половым (через образование аскоспор) и бесполым (через формирование конидий) путём. К аскомицетам относят и дрожжи — одноклеточные грибы, утратившие способность образовывать мицелий. Возбудителям микозов человека выступают Pseudoattescheria boydii и представителей родов Geotrichum, Microsporum и Trichophyton.
Базидиомицеты [от греч. basidon, маленькая основа, + mykes, гриб] имеют характерный орган спороношения — базидий. Последний состоит из вздутой терминальной клетки, расположенной на тонком стебле. На базидий путём мейотического деления развиваются, отшнуровываясь от него, базидиоспоры. Единственным патогенным для человека видом выступает Filobasidiella neoformans (половая форма Cryptococcus neoformans var. neoformans).
Дейтеромицеты [от греч. deuteros, вторичный, + mykes, гриб] не образуют настоящую филогенетическую группу, а выступают в качестве таксономической «свалки», куда помещают виды, у которых половая (совершенная) стадия размножения отсутствует либо не выявлена. Их классификация основана на формах спороношения или других внешних признаках и служит только практическим целям. Для них установленным считают лишь бесполое размножение, поэтому дейтеромицеты также известны как несовершенные грибы (Fungi imperfecti). По морфологическим признакам большинство дейтеромицетов сходно с аскомицетами. Большая часть возбудителей микозов человека входит в группу несовершенных грибов.

Кодекс названий грибов
Кодекс названий грибов содержит положения, предусматривающие присвоение отдельных наименований совершенной (половой, или сумчатой) и несовершенной (бесполой, или конидиальной) стадиям. У многих грибов известны бесполые стадии (анаморфы) и неизвестны половые стадии (телеоморфы). Поэтому кодекс разрешает давать различным стадиям (если таковые есть) различные названия. Например, половые формы дрожжевого гриба Cryptococcus neoformans сероваров А и D систематизируют как Filobasidella neoformans var. neoformans либо как С neoformans var. neoformans. Телеоморфы сероваров В и С — как Filobasidella neoformans var. bacillispora либо как С. neoformans var. gatti.
Классификация (от лат. classis — разряд (класс) и лат. facere — делать) — это система соподчиненных понятий (классов объектов) какой-либо области знания или деятельности, используемая как средство для установления связей между этими понятиями или классами объектов. Научная классификация выражает систему законов, присущих отображённой в ней области действительности. Различают естественные классификации , основа которых — существенные признаки объектов (как периодическая система химических элементов Д. И. Менделеева ), и искусственные классификации (или вспомогательные классификации ), основа которых — несущественные признаки (как алфавитно-предметные указатели или именные каталоги в библиотеках).
Классификация — распределение объектов по разрядам, классам, группам, с тем условием, что в один разряд, группу, класс, попадают объекты, обладающие общим признаком. А систематика (в частности — биологическая систематика) — это научная дисциплина, в задачи которой входит разработка самих принципов классификации живых организмов и практическое приложение этих принципов к построению самой системы их систематики.
Гифальные (плесневые) грибы образуют ветвящиеся тонкие нити (гифы), сплетающиеся в грибницу, или мицелий (плесень). Толщина гиф колеблется от 2 до 100 мкм. Гифы, врастающие в питательный субстрат, называются вегетативными гифами (отвечают за питание гриба), а растущие над поверхностью субстрата — воздушными или репродуктивными гифами (отвечают за бесполое размножение).
Гифы низших грибов не имеют перегородок. Они представлены многоядерными клетками и называются ценоцитными (от греч. koenos — единый, общий).
Гифы высших грибов разделены перегородками, или септами с отверстиями.
Дрожжевые грибы (дрожжи), в основном, имеют вид отдельных овальных клеток (одноклеточные грибы). По типу полового размножения они распределены среди высших грибов — аскомицет и базидиомицет. При бесполом размножении дрожжи образуют почки или делятся, что приводит к одноклеточному росту. Могут образовывать псевдогифы и ложный мицелий (псевдомицелий) в виде цепочек удлиненных клеток — «сарделек». Грибы, аналогичные дрожжам, но не имеющие полового способа размножения, называют дрожжеподобными. Они размножаются только бесполым способом — почкованием или делением. В медицинской литературе понятие «дрожжеподобные грибы» часто идентифицируют с понятием «дрожжи».
Диморфизм грибов . Многие грибы характеризуются диморфизмом — способностью к гифальному (мицелиальному) или дрожжеподобному росту, в зависимости от условий культивирования. Например, в инфицированном организме они растут в виде дрожжеподобных клеток (дрожжевая фаза), а на питательных средах образуют гифы и мицелий. Такая реакция связана с температурным фактором: при комнатной температуре образуется мицелий, а при 37 °С (при температуре тела человека) — дрожжеподобные клетки.
Размножение грибов происходит половым и бесполым (вегетативным) способами. Половое размножение грибов происходит с образованием гамет, половых спор и других половых форм. Половые формы называются телеоморфами.
Бесполое (вегетативное) размножение грибов происходит с образованием соответствующих форм, называемых анаморфами.
Такое размножение происходит почкованием, фрагментацией гиф и бесполыми спорами . Эндогенные споры (спорангиоспоры) созревают внутри округлой структуры — спорангия. Экзогенные споры (конидии) формируются на кончиках плодоносящих гиф, так называемых конидиеносцах.
Основные типы конидий. Артроконидии (артроспоры), или таллоконидии (старое название — оидии, таллоспоры), образуются путем равномерного септирования и расчленения гиф; бластоконидии образуются в результате почкования. Одноклеточные небольшие конидии называются микроконидиями. Многоклеточные, большие конидии называются макроконидиями. К бесполым формам грибов относят также хламидокони- дии, или хламидоспоры (толстостенные крупные покоящиеся клетки или комплекс мелких клеток) и склероции (твердая масса клеток с оболочкой) — покоящиеся органы грибов, способствующие их выживанию в неблагоприятных условиях.
Типы грибов. Выделяют 3 типа (Phylum, см. гл. 2) грибов (табл. 6.1), имеющих половой способ размножения (так называемые совершенные грибы): зигомицеты (Zygomycota), аскомицеты (Ascomycota) и базидиомицеты (Basidiomycota). Отдельно выделяют условный, формальный тип/группу грибов — дейте- ромицеты (Deiteromycota), у которых имеется только бесполый способ размножения (так называемые несовершенные грибы).
Рис. 6.2.Грибы родаRhizopus
Таблица 6.1. Основные представители царства грибов, имеющих медицинское значение»
Плесневые грибы и дрожжи. Строение плесневых грибов
Царство грибов - одно из самых необычных и впечатляющих в мире живой природы. Разнообразие этих организмов действительно впечатляет, а их свойства достойны внимательного изучения. С некоторыми их видами люди сталкиваются каждый день, даже не задумываясь о том, что это грибы. Именно на таких разновидностях и стоит остановиться поподробнее.
Какими бывают грибы?

У этого царства есть сложная классификация. Большинство людей под грибами понимает лишь один их вид, основной - шляпочный. К нему относятся как съедобные, так и ядовитые варианты - шампиньоны, трюфели, боровики, лисички, мухоморы, поганки и множество других.
Другим, еще более интересным видом, являются плесневые грибы. Они отличаются микроскопическими размерами, из-за которых плодовые тела и грибницу практически невозможно заметить невооруженным глазом. Но вообще увидеть их совсем не сложно - достаточно оставить во влажном месте кусок хлеба, и уже скоро на нем появится знакомый всем пушистый налет. Это и есть плесневые грибы, а именно - сапрофиты, несъедобный вид, часто распространяющийся по фруктам, овощам, почве и стенам сырых темных помещений.
Третий вид - дрожжи. Они известны человеку с давних пор и распространены так же, как и плесневые грибы. Например, именно им люди обязаны существованием хлеба, пива, вина и кваса. Плесневые грибы и дрожжи одинаково хорошо размножаются в повседневной для человека среде, но, в отличие от первых, предпочитающих сырость и полумрак, вторые нуждаются в сахаре. Но есть и общее - дрожжи также невозможно рассмотреть в деталях без микроскопа. На сегодняшний день человеку известно 1500 их разновидностей.
Дрожжевые грибы

Такой вид отличается от всех прочих тем, что утратил классическую для царства мицелиальную структуру. Дрожжи живут в жидкой или полужидкой среде, наполненной органическими веществами. Они существуют в виде делящихся или почкующихся клеток. Такое строение позволяет им иметь максимально высокую скорость обмена веществ, поэтому они могут быстро расти и размножаться. Несмотря на то что плесневые грибы и дрожжи кажутся схожими из-за своих микроскопических размеров, у первых все же есть мицелий и все характерные особенности, в то время как последние составляют одну клетку. Интересна история происхождения названия такой разновидности. Слово «дрожжи» связано с дрожью, которую можно заметить на забродившем сусле или поднимающемся тесте.
Особенности плесневых грибов
Данная разновидность сохраняет большинство свойств шляпковых видов. При этом они отличаются микроскопическими размерами. Плесневые грибы образуют тончайший разветвленный мицелий, от которого не отделяются крупные плодовые тела. Они были первыми обитателями планеты Земля, на которой появились более двухсот миллионов лет назад. Мицелий плесневого гриба развивается практически во всех условиях в природе, независимо от наличия пищи и особенностей среды обитания. Громадные колонии моментально возникают при наличии влажности и достаточно высокой температуры.
Виды плесневых грибов очень многочисленны, но у них есть общие черты - основой служит мицелий, а тонкие ветвящиеся нити размещаются прямо внутри пораженной поверхности. В отличие от дрожжей, они размножаются половым или вегетативным путем. Клетка плесневого гриба не составляет всего его тело. Впрочем, это не мешает им распространяться с огромной скоростью.
Самые известные плесневые грибы

Некоторые из представителей царства важнее для человечества, чем другие. Это плесневые грибы пеницилл, представляющие собой зеленые пятна, разрастающиеся на растительных субстратах и обычных пищевых продуктах. Из них продуцируется антибиотик под названием пенициллин, который был первым в мире антибактериальным препаратом. Его изобретение изменило мир медицины. И плесневые грибы, и бактерии могут приносить вред человеческому здоровью. Но разновидность под названием пеницилл может спасать жизни, чем и заслужила свою широчайшую известность.
Класс фикомицетов
Одним из самых распространенных видов являются Phycomycetes, или плесневые грибы мукор. В данном семействе насчитывается более трехсот разновидностей. Самыми распространенными являются три: Mucor, Thamnidium и Rhizopus. Строение плесневых грибов мукор отличается тем, что их мицелий часто состоит из одной разветвленной клетки. От нее отходят воздушные шарообразные гифы, наполненные множеством спор. Распространение мукоровых происходит легко и быстро на многих видах субстрата, за исключением молочных продуктов, и прекращается лишь при температурах, которые ниже -8 градусов по Цепьсию.
Класс аскомицетов
Именно к этому семейству относятся грибы пеницилл, а также некоторые другие, к примеру, рода Aspergillus. Иначе этот класс называют сумчатыми. В то время как плесневые грибы мукор образуют примитивный одноклеточный мицелий, аскомицеты отличаются более сложной структурой, которая быстро образует отдельные друг от друга колонии, разрастающиеся по субстрату. На ней моментально формируются споры, которым плесень и обязана своим пушистым видом серовато-зеленого цвета. При изучении в микроскоп причины названия становятся очевидны - строение плесневых грибов включает длинные цепочки конидий, содержащих споры, которые и образуют кисточку или сумку. Идеальными условиями для развития являются сырость и плохая вентиляция при температуре, близкой к 0 градусов по Цельсию.
Отличие Aspergillus от Penicillum
Находящиеся в одном семействе, эти плесневые грибы похожи по внешнему виду. У них бесцветный мицелий с цветными конидиями шаровидной формы, как правило, они отличаются серовато-синим или серо-зеленым оттенком, реже с желтым подтоном. Тем не менее, роль плесневых грибов aspergillus заметно отличается. В то время как пенициллин служит важным компонентом лекарственных средств, в родственном пеницилловым виде содержатся вещества, вызывающие порчу молочных или мясных продуктов.
Несовершенные грибы
Этот класс изучен не столь широко, как описанные выше. Несовершенные виды плесневых грибов размножаются отличным от полового способом, неизвестным в деталях. Их отличает септированный мицелий с гроздевидными спорами темной окраски. Из-за этого поражение такими грибами образует черные бархатистые пятна. Подобная плесень хорошо развивается при низких температурах и отличается большой зоной поражения - при появлении на мясе она проникает глубоко в мышечную ткань. Именно эти грибы могут приводить к внутреннему плесневению, портят масло, сыр, яичные продукты.
Молочная плесень
Грибы разновидности Oidium lactis напоминают своим строением дрожжевые. У них белый септированный мицелий с отделенными спорами в виде одиночных клеток. Питание плесневых грибов этого вида включает разнообразные молочные продукты. Их появление проявляется в виде пушистого налета белого цвета, который может покрывать поверхность сметаны, простокваши или творога. Плесень снижает их кислотность, отчего продукт портится. Некоторые ученые относят их к дрожжам в силу простоты клеточных цепочек и войлокообразного мицелия.
Плесень, которая размножается в холодильнике
Поражать продукты, которые хранятся при достаточно низкой температуре, могут несколько разновидностей грибов. В первую очередь это Botrytis, отличающийся стелющимся мицелием войлокообразного вида, с бесцветными конидиями, появляющимися пучками. К плесневым грибам относят также те, что отличаются коричневыми или оливковыми конидиеносцами. Подобный вид развивается в холодильнике при температуре ниже 5 градусов по Цельсию и поражает разнообразные продукты. Другим опасным для еды видом является Alternaria. К ним относят грибы с грушевидными или заостренными конидиями бурого или оливкового цвета. Такая плесень может поражать не только охлажденное, но и замороженное мясо, а также масло и другие продукты питания.
Класс Фома
Эти плесневые грибы отличаются от всех прочих оригинальным строением. Они не образуют наружного мицелия и чаще всего развиваются внутри субстрата, проходящего процесс гниения. Для размножения плесневые грибы Phoma используют короткие конидиеносцы с переплетенными гифами, окружающими их, как оболочку.
Как плесень воздействует на человеческий организм?
Далеко не все виды грибов так полезны для человечества, как пеницилловые. Чаще дело обстоит совсем наоборот, и появление плесени является недобрым знаком. Прежде всего, ее споры очень негативно воздействуют на слизистые оболочки организма, вызывая иммунные реакции. Это один из самых сильных аллергенов, и у людей с определенными проблемами в этой области гарантировано будет дискомфорт при малейшем контакте с плесенью. И дело не только в кратковременной реакции - со временем все может закончиться серьезными заболеваниями. В домах, пораженных плесневыми грибами, заболевают астмой восемь из десяти жильцов. Цифра весьма впечатляющая. И это далеко не все возможные проблемы.
У человека с ослабленным иммунитетом могут быть и другие заболевания. Почти тысяча видов грибков могут паразитировать на человеке или домашних животных, провоцируя болезни кожи, волос или ногтей - стригущий лишай, кандидоз, бластомикоз и другие.
Даже не затрагивая здоровье человека, плесень может принести серьезный вред. Например, паразитирующие на животных и растениях грибы могут распространяться и на пищевые продукты, материалы и изделия из кожи, на бумагу, пластмассу и дерево, произведения искусства, чем неизбежно вызовут повреждение пораженной области. Такая плесень может нанести огромный ущерб.
Как бороться с плесенью в доме?
Если возникла такая проблема, необходимо как можно скорее задуматься о способах уничтожения грибов. Для этого следует воспользоваться специальным антисептиком, который можно приобрести в магазине стройматериалов. Работать с ним необходимо максимально осторожно, изучив инструкцию по применению. Кроме того, перед началом борьбы с плесенью стоит осмотреть, насколько глубоко поражена поверхность. Иногда зараженный предмет лучше выкинуть. Если же поражение не так уж масштабно, можно приступать к действиям. В первую очередь обратите внимание на антисептическую грунтовку. Она не только уничтожит плесень, но и предотвратит ее повторное появление. Использовать такое средство достаточно просто, чаще всего не нужно даже разбавлять водой. Рекомендуется только очистить поверхность перед обработкой.
Если возможности или желания искать специальное средство нет, стоит обратиться к домашним способам. Например, отличным вариантом может оказаться отбеливатель. Содержащийся в нем гипохлорит натрия убивает не только плесень, но и ее споры. Отбеливатель идеально подойдет для случаев, когда нужно очистить плитку в ванной, пол или стекло. Но для других предметов он может быть опасен - многие вещи теряют цвет или портятся от такой обработки. К тому же, отбеливатель достаточно токсичен, поэтому использовать его стоит только в помещении, которое хорошо проветривается, вооружившись защитными резиновыми перчатками.
Менее опасен в таких случаях уксус. Он не настолько токсичен, поэтому его можно использовать без опасений. Использовать уксус стоит с помощью распылителя или смачивая в нем тряпку и протирая пораженную плесенью поверхность.
Для твердых поверхностей вроде плитки и стекла также подойдет нашатырный спирт. Достаточно в равных пропорциях смешать его с водой и распылить смесь по всей зараженной области, а через несколько часов промыть ее водой.
Самым безопасным средством станет пищевая сода. Она не навредит ни членам семьи, ни домашним животным. Для борьбы с плесенью чайная ложка соды растворяется в стакане воды, после чего смесью можно опрыскивать пораженные поверхности. Смывать раствор необязательно - он будет профилактическим средством.
Читайте также:
- Показания, доступ и ход операции спленэктомии при спленомегалии
- КТ, МРТ при остром кальцифицирующем тендините сухожилия длинной мышцы шеи
- Алгоритм обследования при краниосиностозе по Европейским рекомендациям
- Инородные тела роговицы. Диагностика
- Артериовенозный свищ у детей. Гемодинамика при артериовенозном свище.
